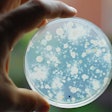

Turmeric is commonly considered a spice and is permitted in pet food for use as a coloring additive. | (tarapong srichaiyos | shutterstock.com)
Turmeric has been finding its way into pet foods with increasing frequency in the past few years. There are dozens of websites and online news outlets describing many positive attributes of turmeric for pets. It is purported to have a wide variety of health benefits.